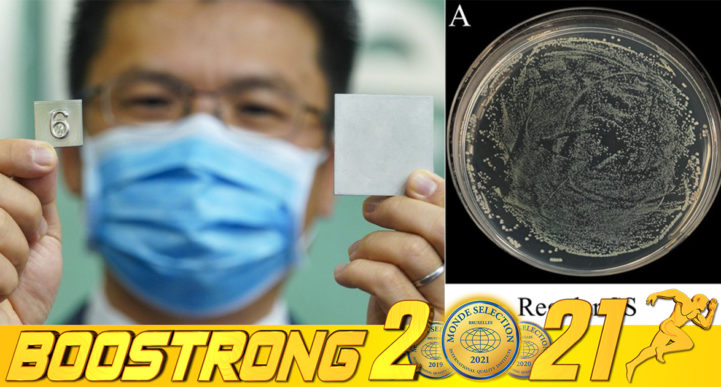

- autoadmin
- កូវីដ-១៩
ចំនួនករណីជំងឺ COVID-19 នៅឯសហរដ្ឋអាមេរិក បានកើនដល់ ៥០លានករណី គិតត្រឹមថ្ងៃអាទិត្យ ទី១២ ខែធ្នូ ឆ្នាំ២០២១ នេះបើយោងតាមរបាយការណ៍របស់ រ៉យទ័រ ខណៈដែលវ៉ារ្យ៉ង់ ដែលតា បានបន្តគំរាមកំហែងដល់ប្រជាជនអាមេរិក ហើយវ៉ារ្យ៉ង់ អូមីក្រុង ក៏កំពុងបន្ថែមបន្ទុកដល់ប្រទេសមួយនេះ។ បន្ទាប់ពីរយៈពេល ២ខែ នៃការថយចុះករណីនៃការឆ្លងថ្មីៗ សហរដ្ឋអាមេរិកបានចាប់ផ្ដើមមើលឃើញពីការកើនឡើងនូវការឆ្លងឡើងវិញក្នុងចំនួនច្រើន ហើយភាគច្រើនគឺជាវ៉ារ្យ៉ង់ ដែលតា តែម្ដង។ ជាក់ស្ដែងរដ្ឋមួយចំនួននៅតំបន់ត្រជាក់ កំពុងមើលឃើញពីការកើនឡើងក្នុងចំនួនច្រើន រួមមានរដ្ឋ Vermont, New Hampshire និង Michigan។ ចំណែកចំនួនអ្នកជំងឺ COVID ដែលសម្រាកព្យាបាលនៅមន្ទីរពេទ្យក៏កំពុងកើនឡើងផងដែរ
December 13, 2021 - កូវីដ-១៩
យោងតាមការចុះផ្សាយរបស់សារព័ត៌មាន Vietnam Plus បានរាយការណ៍ថា ប្រទេសវៀតណាមបានកត់ត្រាករណីជំងឺ COVID-19 ថ្មីចំនួន ១៤,៦៣៨ ករណី ចេញពីក្នុងទីក្រុង និងខេត្តចំនួន ៥៨ កាលពីយប់ថ្ងៃអាទិត្យ ទី១២ ខែធ្នូ ឆ្នាំ២០២១។ ក្នុងចំណោមអ្នកជំងឺដែលបានបញ្ជាក់កាលពីថ្ងៃអាទិត្យ ភាគច្រើនគឺនៅទីក្រុងហូជីវិញ ដែលមាន ១,២១៦ ករណី បន្ទាប់មកគឺទីក្រុងហាណូយ ៩៨០ ករណី និងខេត្ត Tay Ninh មានចំនួន ៩២០ ករណី។ ការស្លាប់ដោយសារជំងឺ COVID-19 ថ្មីចំនួន ២២៨ ករណី ដែលនាំឱ្យចំនួនអ្នកស្លាប់សរុបរបស់ប្រទេសនេះ
December 13, 2021 - អន្តរជាតិ
អាជ្ញាធរសុខាភិបាលអង់គ្លេសបាននិយាយថា ការសិក្សាជាបឋមបានបង្ហាញថា ការចាក់វ៉ាក់សាំងបង្ការជំងឺ COVID-19 ដូសជំរុញ នឹងផ្តល់ការការពារពី ៧០ ទៅ ៧៥% ប្រឆាំងនឹងវ៉ារ្យ៉ង់ Omicron (អូមីក្រុង) ដែលមានចេញរោគសញ្ញា។ ទីភ្នាក់ងារសន្តិសុខសុខភាពកាលពីថ្ងៃសុក្របានចេញផ្សាយលទ្ធផលដំបូងនៃការសិក្សារបស់ខ្លួន ដែលបានធ្វើការសិក្សាលើមនុស្ស ៥៨១នាក់ ពាក់ព័ន្ធនឹងវ៉ារ្យ៉ង់ Omicron ហើយក្នុងចំណោមអ្នកចូលរួមមួយចំនួន គឺបានទទួលថ្នាំបង្ការចំនួន ២ដង ខណៈអ្នកផ្សេងទៀតបានចាក់ដូសជំរុញរួចរាល់។ លទ្ធផលបានបង្ហាញថា អ្នកដែលបានចាក់វ៉ាក់សាំង ២ដូស មានកម្រិតប្រឆាំងនឹងរោគសញ្ញានៃវ៉ារ្យ៉ង់ Omicron ទាបជាង បើប្រៀបនឹងវ៉ារ្យ៉ង់ Delta ។ ជាមួយគ្នានេះដែរ ពី ៧០
December 11, 2021 - កូវីដ-១៩
ក្រសួងសុខាភិបាលវៀតណាមបានបញ្ជាក់ពីករណីជំងឺ COVID-19 ថ្មីចំនួន ១៤,៨១៩ ករណី កាលពីយប់ថ្ងៃសុក្រ ទី១០ ខែធ្នូ ឆ្នាំ២០២១ ដែលជំរុញឱ្យចំនួនឆ្លងនៅក្នុងរលកទី០៤ ដែលកំពុងបន្តកើនឡើង មានដល់ ១ ៣៧៦ ០១៧ ករណី។ មូលដ្ឋានចំនួន ៣ ដែលមានចំនួនករណីថ្មីខ្ពស់បំផុត គឺទីក្រុងហូជីមិញមាន ១,២២៦ ករណី, ក្រុង Soc Trang មាន ៨៩៤ ករណី និង Tay Ninh មាន ៨៩៣ ករណី។
December 11, 2021 - អន្តរជាតិ
យោងតាមការចុះផ្សាយរបស់សារព័ត៌មាន South China Morning Post បានរាយការណ៍ថា អ្នកជ្រាវជ្រាវមួយក្រុមមកពីទីក្រុងហុងកុង បានបង្កើតដែកអ៊ីណុកប្រភេទថ្មីមួយ ដែលអាចសម្លាប់មេរោគ COVID-19 លើផ្ទៃរបស់វា ក្នុងរយៈពេលប៉ុន្មានម៉ោងប៉ុណ្ណោះ។ វាត្រូវបានគេរំពឹងថា នឹងវាយលុកទីផ្សារក្នុងរយៈពេល ៦ខែ ខាងមុខនេះ ដោយវានឹងធ្វើការកាត់បន្ថយហានិភ័យនៃការឆ្លងមេរោគ ដែលនៅជាប់នឹងកូនសោទ្វារ ប៊ូតុងជណ្ដើរប្រអប់ និងកន្លែងមានការប៉ះពាល់ច្រើនផ្សេងទៀត។ វាគឺជាដែកថែបប្រឆាំងមេរោគ COVID-19 ដំបូងគេរបស់ពិភពលោក ជាមួយនឹងការរួមផ្សំរវាងទង់ដែង និងលោហធាតុ ដែលធ្វើឱ្យកោសិកាមេរោគ COVID-19 នឹងត្រូវអសកម្ម ៩៩.៧៥% នៅក្នុងរយៈពេល ៣ម៉ោង និង ៩៩.៩៩% ក្នុងរយៈពេល ៦ម៉ោង ខណៈដែលជាធម្មតាមេរោគ
December 11, 2021 - កូវីដ-១៩
ប្រទេសវៀតណាមកាលពីយប់ថ្ងៃព្រហស្បតិ៍ ទី០៩ ខែធ្នូ ឆ្នាំ២០២១ បានកត់ត្រាករណីជំងឺ COVID-19 ក្នុងសហគមន៍ចំនួន ១៥,៣០០ ករណី ដែលជាចំនួនឆ្លងប្រចាំថ្ងៃខ្ពស់បំផុតក្នុងរយៈពេលជិត ៣ខែ ដែលធ្វើឱ្យចំនួននៃការឆ្លងនៅក្នុងរលកទី០៤ រហូតមកដល់ពេលនេះគឺមាន ១,៣៦១,១៩៨ ករណី។ តំបន់ចំនួន ៣ ដែលមានចំនួនអ្នកឆ្លងខ្ពស់បំផុតគឺ ទីក្រុងហូជីមិញមាន ១,៤៥៣ ករណី, ក្រុងតាយនិញ ៨៩៥ ករណី និងទីក្រុងហាណូយ ៨២២ ករណី។ ការស្លាប់ចំនួន ២៥៦ ករណី ត្រូវបានបន្ថែមទៅក្នុងទិន្នន័យជាតិនៅថ្ងៃដដែល ដែលនាំឱ្យការស្លាប់សរុបកើនឡើងដល់ ២៧,១៨៦ ករណី
December 10, 2021 - អន្តរជាតិ
យោងតាមការចុះផ្សាយរបស់សារព័ត៌មាន រ៉យទ័រ បានរាយការណ៍ថា និយតករសហរដ្ឋអាមេរិកកាលពីថ្ងៃព្រហស្បតិ៍ បានពង្រីកសិទ្ធិទទួលបានការចាក់វ៉ាក់សាំងបង្ការជំងឺ COVID-19 ដូសទី៣ ដល់ក្មេងអាយុ ១៦ និង ១៧ឆ្នាំ ខណៈដែលមន្ត្រីសុខាភិបាលសាធារណៈក៏កំពុងជំរុញឱ្យជនជាតិអាមេរិក ទៅទទួលការចាក់វ៉ាក់សាំងលើកទី៣ ដោយសារការព្រួយបារម្ភអំពីវ៉ារ្យ៉ង់ថ្មីគឺ Omicron ។ រដ្ឋបាលចំណីអាហារ និងឪសថអាមេរិក បាននិយាយថា ខ្លួនបានធ្វើវិសោធនកម្មការអនុញ្ញាតប្រើប្រាស់ជាបន្ទាន់របស់ខ្លួន លើវ៉ាក់សាំងដូសទី៣ របស់ក្រុមហ៊ុន Pfizer Inc (PFE.N) និងវ៉ាក់សាំង BioNTech SE ដើម្បីអនុញ្ញាតឱ្យយុវជន ដែលមានអាយុពី ១៦ – ១៧ឆ្នាំ ទទួលការចាក់វ៉ាក់សាំងលើកទី៣ យ៉ាងហោចណាស់ប្រាំមួយខែ
December 10, 2021 - អន្តរជាតិ
ក្រុមអ្នកស្រាវជ្រាវនៅក្នុងប្រទេសជប៉ុនបាននិយាយថា មេរោគ COVID-19 វ៉ារ្យ៉ង់ថ្មី Omicron គឺអាចឆ្លងបានឆាប់រហ័ស សូម្បីតែក្នុងចំណោមអ្នកទទួលថ្នាំបង្ការ ឬអ្នកដែលធ្លាប់បានឆ្លងមេរោគ COVID-19 ប្រភេទមុនៗក៏ដោយ។ វាគឺជាការរកឃើញដោយក្រុមមួយ ដែលដឹកនាំដោយសាស្រ្តាចារ្យសាកលវិទ្យាល័យក្យូតូលោក Nishiura Hiroshi ដែលបានរាយការណ៍ពីលទ្ធផលនៃការវិភាគរបស់ពួកគេលើការរីករាលដាលយ៉ាងឆាប់រហ័សនៃវ៉ារ្យ៉ង់ Omicron នៅក្នុងប្រទេសអាហ្វ្រិកខាងត្បូង នៅឯកិច្ចប្រជុំនៃក្រុមប្រឹក្សាយោបល់ទៅកាន់ក្រសួងសុខាភិបាលកាលពីថ្ងៃពុធថ្មីៗនេះ។ ក្រុមរបស់គាត់បានពិនិត្យព័ត៌មានហ្សែននៃករណីប្រហែល ២០០ ករណី ដែលបានរាយការណ៍ពីប្រទេសអាហ្វ្រិកខាងត្បូង ចាប់ពីខែកញ្ញាដល់ចុងខែវិច្ឆិកា ដោយផ្អែកលើមូលដ្ឋានទិន្នន័យអន្តរជាតិ។ ពួកគេនិយាយថា អត្រាបន្ដចម្លងរបស់មេរោគមកលើមនុស្សគឺខ្ពស់ជាង ៤.២ដង (ចំនួនជាមធ្យមសម្រាប់មនុស្សម្នាក់) សម្រាប់វ៉ារ្យ៉ង់ Delta នៅក្នុងខេត្ត Gauteng ដែលរងការវាយប្រហារយ៉ាងខ្លាំងដោយវ៉ារ្យ៉ង់ Omicron
December 10, 2021 - កូវីដ-១៩
យោងតាមការចុះផ្សាយរបស់សារព័ត៌មាន VNExpress បានរាយការណ៍ថា ក្រសួងសុខាភិបាលវៀតណាមបានកត់ត្រាករណីជំងឺ COVID-19 ថ្មីចំនួន ១៤,៥៩៥ ករណី និងការស្លាប់ចំនួន ២៣០ ករណី កាលពីយប់ថ្ងៃពុធ ទី០៩ ខែធ្នូ ឆ្នាំ២០២១ ចេញពីក្នុងទីក្រុង និងខេត្តចំនួន ៥៨ របស់ខ្លួន។ ករណីថ្មីភាគច្រើនត្រូវបានរកឃើញនៅទីក្រុងហូជីមិញ ដែលមានចំនួន ១,៤៧៥ ករណី បន្ទាប់មកខេត្ត Tay Ninh ភាគខាងត្បូងមាន ៨៧៤ ករណី និងក្រុង Soc Trang មាន ៧៨១ ករណី។ ចាប់តាំងពីជំងឺរាតត្បាតបានចាប់ផ្តើមកាលពីឆ្នាំមុន
December 9, 2021 - អន្តរជាតិ
និយតករវេជ្ជសាស្រ្ដរបស់ប្រទេសចិនបានអនុម័តថ្នាំអង្គបដិប្រាណរបស់ក្រុមហ៊ុន Brii Biosciences សម្រាប់ការព្យាបាលជំងឺ COVID-19 លើមនុស្សពេញវ័យ និងមនុស្សវ័យជំទង់ ដែលធ្វើឱ្យវាក្លាយជាថ្នាំអង្គបដិប្រាណដំបូងបំផុត ដែលទទួលបានការអនុញ្ញាតឱ្យមានការប្រើប្រាស់នៅក្នុងប្រទេសចិន។ រដ្ឋបាលផលិតផលវេជ្ជសាស្ត្រជាតិចិន បាននិយាយនៅក្នុងសេចក្តីថ្លែងការណ៍មួយថា ការរួមបញ្ចូលគ្នារវាងថ្នាំ BRII-196/BRII-198 គឺសម្រាប់ការព្យាបាលជំងឺ COVID-19 កម្រិតស្រាល និងជាទូទៅ សម្រាប់អ្នកដែលមានហានិភ័យទៅជាឈឺធ្ងន់ធ្ងរ។ វាត្រូវបានអនុម័តសម្រាប់ទាំងមនុស្សពេញវ័យ និងអនីតិជន ដែលមានអាយុចន្លោះពី ១២ ទៅ ១៧ឆ្នាំ។ ក្រុមហ៊ុនឱសថ Brii Biosciences បានអះអាងថា ការសាកល្បងដំណាក់កាលទី៣ របស់ថ្នាំលាយបញ្ចូលគ្នា BRII-196/BRII-198 បានបង្ហាញថា វាអាចការបន្ថយការចូលមន្ទីរពេទ្យ និងអត្រាការស្លាប់បាន
December 9, 2021